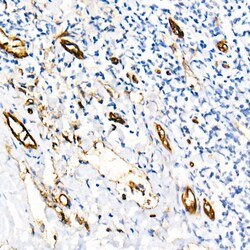

Promotional price valid on web orders only. Your contract pricing may differ. Interested in signing up for a dedicated account number?
Learn More
Learn More
Invitrogen™ CD31 (PECAM-1) Recombinant Rabbit Monoclonal Antibody (2V8C4)


Rabbit Recombinant Monoclonal Antibody
Supplier: Invitrogen™ MA538125
Description
Positive Samples: THP-1, Mouse lung Immunogen sequence: AKQMPVEMSR PAVPLLNSNN EKMSDPNMEA NSHYGHNDDV RNHAMKPIND NKEPLNSDVQ YTEVQVSSAE SHKDLGKKDT ETVYSEVRKA VPDAVESRYS RTEGSLDGT.
CD31 (platelet endothelial cell adhesion molecule-1, PECAM-1) is an inhibitory coreceptor involved in regulation of T cell and B cell signaling by a dual immunoreceptor tyrosine-based inhibitory motif (ITIM) that upon associated kinases-mediated phosphorylation provide docking sites for protein-tyrosine phosphatases. CD31 is expressed ubiquitously within the vascular compartment and is located mainly at junctions between adjacent cells. N-terminal Ig-like domain of CD31 is responsible for its homophilic binding, which plays an important role in cell-cell interactions. CD31 is a multifunctional molecule with diverse roles in modulation of integrin-mediated cell adhesion, transendothelial migration, angiogenesis, apoptosis, negative regulation of immunoreceptor signaling, autoimmunity, macrophage phagocytosis, IgE-mediated anaphylaxis and thrombosis. It is one of key regulatory molecules in vascular system.
Specifications
| CD31 (PECAM-1) | |
| Recombinant Monoclonal | |
| 0.55 mg/mL | |
| PBS with 0.05% BSA, 50% glycerol and 0.05% ProClin 300; pH 7.3 | |
| P16284, Q08481 | |
| Pecam1 | |
| Recombinant protein (or fragment). | |
| 100 μL | |
| Primary | |
| Human, Mouse | |
| Antibody | |
| IgG |
| ELISA, Immunohistochemistry (Paraffin), Western Blot, Immunocytochemistry | |
| 2V8C4 | |
| Unconjugated | |
| Pecam1 | |
| C85791; CD31; CD31 antigen; CD31, PECAM-1; CD31/EndoCAM; endoCAM; GPIIA'; I79_008304; PECA1; Pecam; PECAM1; Pecam-1; platelet and endothelial cell adhesion molecule 1; platelet endothelial cell adhesion molecule; platelet endothelial cell adhesion molecule-1; platelet/endothelial cell adhesion molecule (CD31 antigen); platelet/endothelial cell adhesion molecule 1; type I transmembrane endothelial adhesion molecule | |
| Rabbit | |
| Affinity chromatography | |
| RUO | |
| 18613, 5175 | |
| -20°C, Avoid Freeze/Thaw Cycles | |
| Liquid |
Safety and Handling
WARNING: Cancer - www.P65Warnings.ca.gov
Product Content Correction
Your input is important to us. Please complete this form to provide feedback related to the content on this product.
Product Title
Spot an opportunity for improvement?Share a Content Correction